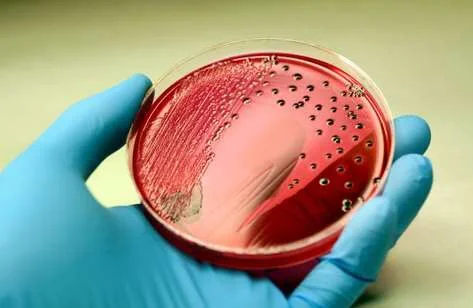

Бластоцисты Немозол

🛑 👉🏻👉🏻👉🏻 ВСЯ ИНФОРМАЦИЯ ДОСТУПНА ЗДЕСЬ, ЖМИ 👈🏻👈🏻👈🏻
НЕМОЗОЛ таблетки - инструкция по применению, цена . . .
Немозол инструкция по применению: показания . . .
лечение немозолом (бластоцистоз) . Помогите понять схему . . .
Бластоцисты- вредная неизлечимая гадость — 17 ответов . . .
Немозол - 28 отзывов, инструкция по применению
, бластоцисты - лечение - Вопрос инфекционисту - 03 Онлайн
бластоцист - Перевод на английский - примеры русский . . .
Таблетки от паразитов немозол — Заболевание желудка
Бластоцисты - Инфекционные и паразитарные болезни - 12 .09 . . .
Бластоцисты или 7 кругов — 7 ответов врачей на вопрос на . . .
Моксонидин Под Язык Или Внутрь Как Лучше
Лидокаин Процент
Моксифлоксацин Лечение Простатита Отзывы
Инструкция по применению препарата НЕМОЗОЛ таблетки: дозировки, побочные эффекты . . .
Немозол, таб . жевательные 400 мг . Показания, противопоказания, режим дозирования, побочное . . .
с 8 дня подключать немозол 10,0 или 1/2 таблетки - 1 раз в день ,7 дней . После того, как всё это пропьем: бифилиз - 5 доз, 2 раза в день, до еды . 2-4 недели . Пропили мы неделю хафитол и лакофильтрум .
Пролечились Немозолом 5 дней по схеме врача, живот так и не проходит . мы уже диету сменили, думали, что дочка просто не хочет одна по вечерам засыпать, все просит ей животик вылечить . Сдали повторный аназиз после лечения - бластоцисты опять . . . .
Немозол (Nemozole): 17 отзывов врачей, 11 отзывов пациентов, инструкция по применению, аналоги . . .
В кале обнаружили blastocystis spp . 3-4-3-2-4-3 прописали немозол 6дней, мезим, цетрин и полисорб, 6 дней лечение, 7 дн . Перерыв, 6дн опять лечение и нельзя употреблять никакие углеводы .
Перевод контекст "бластоцист" c русский на английский от Reverso Context: Например, в одном исследовании получить секретом отпечатков пальцев для многих бластоцист и найти 9 белков, которые могут различаться у бластоцист с . . .
Немозол для профилактики взрослым как принимать Как правильно принимать немозол взрослым отзывы Описание и инструкция Немозола Немозол - это препарат для лечения гельминтных инвазий,
Консультация на тему - Бластоцисты - Добрый день! У ребенка в 5 мес (анализ сдавали в мае 2015) при сдаче Копрологии обнаружены простейшие бластоцисты + . Педиатр рекомендовала посетить Гельминтолога (на данный период . . .
Ответ врача о вопросе - бластоцисты или 7 кругов Бластоцисты или 7 кругов — 7 ответов врачей на вопрос на сайте СпросиВрача
Нурофен Таблетки Отзывы Врачей
Эуфиллин Аллергические Реакции
Синупрет Видаль
Протаргол В Нос Аналоги
Кординик 10 От Чего Помогает
Утрожестан Згт Отзывы
Альфа Токоферол Инструкция Цена
Бронхобос 375 Цена Таблетки
Диклофенак Гель Обезболивающее
Крем Метрогил Дента
Гидрохлоротиазид 12 50 Мг
Стрептоцид От Заложенности Носа Отзывы
Небидо Нижний Новгород
Крым Источник Косьмы И Дамиана
Бруснивер При Пиелонефрите Можно
Ксалаком Рлс
Беклометазон Формотерол 100 6 Цена Аналог
Когда Начинает Действовать Оланзапин Отзывы
Просульпин 200 Мг Инструкция По Применению
Прадакса 60
Кларитромицин Эко Цена
Тонзилгон Н Для Взрослых
Тагиста Таблетки Для Чего Применяется Взрослым
Рузов Читать
Низорал Или Сульсена Что Лучше Отзывы
Тетрациклин Свечи В Гинекологии
Мед Препарат Терафлекс
Применение Фороз
Лахезис Модальности
Регидрон Аналоги Список
Новатрон Ингаляции
Норколут Инструкция Отзывы Врачей
Мидокалм Форум Пациентов Принимавших Препарат И Врачей
Цинковая Мазь Или Паста Отличие
Нолицин Во Время Беременности
Толокнянка Красная
Лизобакт В Кемерово
Индапамид Ретард 1.5 Мг Цена
Каталина Отальваро Анал
Залаин Цена Воронеж
Гинкго Билоба Трава Польза
Левомицетин Цена В Москве
Гриппферон Пшикалка Цена
Лишай Лечение Флуконазолом
Гино Тардиферон Инструкция
Нифуроксазид Эколаб Отзывы Для Детей
Хитозан Отзывы Тяньши Капсулы
Солкосерил Мазь Цена В Аптеке Омск
Дюфалак Цена СПб Сироп
Флемоклав Солютаб 125 Аналоги
Стрепсилс Похожие
Дипроспан Уколы От Чего Помогает Отзывы Цена
Фосфо Сода Перед Колоноскопией
Пантогам Фитоседан Ново Пассит Персен
Редуксин Форте Барнаул
Календула Можно В Нос
Ион В Растворе Ион Кальция
Маска Со Спирулиной Отзывы
Ребагит Влияние На Сердце
Пертуссин Сироп Для Детей 2 Года
Препараты От Грибка Ногтей Тербинафин
Триожиналь Капсулы Инструкция По Применению
Фенхель Лекарственное Растение
Цифран Цена Уфа
Экоклав Для Чего Назначают Взрослым Таблетки
Престариум 20мг
Цветки Календулы Цена
Пентоксифиллин Взаимодействие С Алкоголем
Ацикловир Реневал 400
Мексидол 125 Мг Цена 50
Сколько Капель Фенистила Принимать Взрослому
Рибоксин Вся Правда
Магний Плюс Шипучие Таблетки Цена
Сколько Ибупрофена На 1 Кг Веса Ребенка
Индометацин Свечи Простатит Дней
Пиколинат Хрома Солгар Как Применять
Метронидазол При Ангине Можно
Редуксин Цена В Абакане
Citilux Марена
Гемицеллюлаза Желчи Компоненты Панкреатин
Куркумин Солгар Цена Отзывы
Депренорм 35 Цена В Москве
Прогинова Горздрав
Аналог Одестона В Таблетках Цена
Можно Дать Коту Смекту При Поносе
Нимесил Раствор
Триптофан При Депрессии И Неврозе
Полижинакс Или Тержинан Форум
Омепразол Цена Чита
Мастодинон 120
Омнитус Сироп От Кашля Взрослым
Санорин Можно Беременным
Простагут Форте 60
Структум 500мг
Каланхоэ Каландива Уход
Кашель И Температура Таблетка
Осельтамивир Против Омикрона Отзывы
Пиперазин Как Действует
Флуконазол Отзывы От Грибка Ротовой Полости
Магазин Диабетон Москва
Бластоцисты Немозол